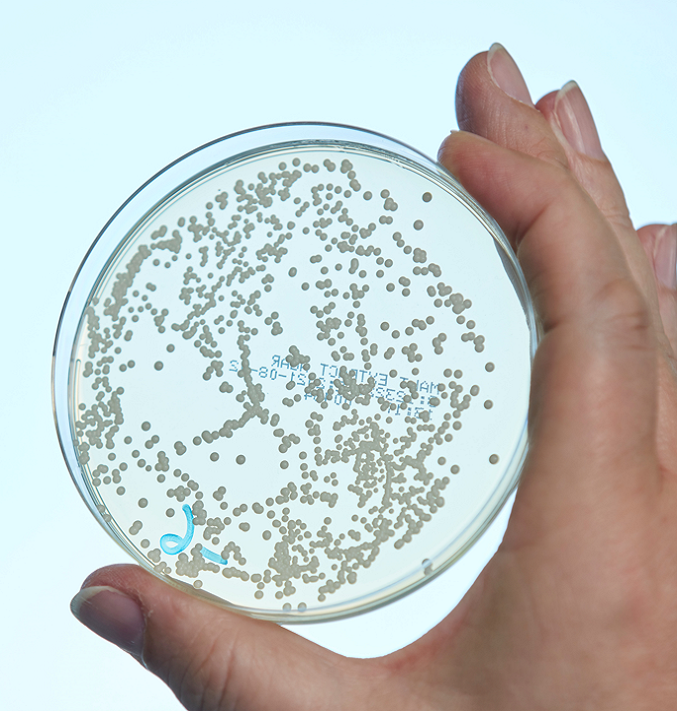

DESINFACTS

Postoperative Wundinfektionen (surgical site infections, SSI), also Infektionen, die im Anschluss an Operationen auftreten, können oberflächlich sein oder tiefer liegende Gewebe, Organe und implantierte Materialien betreffen. Sie werden am häufigsten von pathogenen Bakterien verursacht, seltener durch Viren oder Pilze. Welche Erreger SSI verursachen, hängt im Allgemeinen von der durchgeführten Operation ab [1, 2]. So werden beispielsweise fakultative Erreger erst in Kombination mit zusätzlichen Faktoren, wie dem Einsetzen eines Implantats, problematisch.
Dieser Artikel gibt eine Übersicht über die wichtigsten bakteriellen Erreger, die SSI auslösen.
In Deutschland ist der häufigste Erreger von SSI S. aureus [1]. Die vom Nationalen Referenzzentrum für nosokomialen Infektionen (NRZ) im Rahmen des Krankenhausinfektions-Surveillance-Systems (KISS) erhobenen Daten zeigen, dass S. aurerus in 20 % aller SSI-Isolate zu finden ist [1]. Auch in Daten aus den USA, die im National Healthcare Safety Network (NHSN) des Centers für Disease Control and Prevention (CDC) erfasst wurden, wurde S. aureus in 20,7 % aller SSI-Fälle nachgewiesen [2]. SSI mit S. aureus sind besonders häufig nach kardiologischen und orthopädischen Eingriffen [1]. Ein wichtiger Risikofaktor ist die Besiedlung der Nase des Patienten mit S. aureus, die durch präoperatives Screening und Dekolonisierung angegangen werden kann [1].

In der Abdominalchirurgie hingegen spielen Darmbakterien bei SSI eine besonders wichtige Rolle. Hier ist E. coli mit 30% (NRZ) bzw. 19,6% (NHSN) der SSI-Fälle der häufigste Erreger, gefolgt von Enterokokken (NRZ 29%, NHSN 13,9%) [1, 2]. Eine präoperative Darmentleerung in Kombination mit Antibiotika kann dieses Risiko bei bestimmten Operationen reduzieren [1].
Orthopädische Operationen bergen ein besonders hohes Risiko einer Osteomyelitis (Knocheninfektion hervorgerufen durch Infektionen die sich aus dem umliegenden Gewebe ausbreiten, systemische Bakteriämie oder direktes Knochentrauma), die meist durch S. aureus oder Koagulase-negative Staphylokokken (CoNS) aus der normalen Hautflora verursacht wird [3]. Propionibacterium acnes verursacht häufig SSI nach Schulteroperationen, da dieses Bakterium bevorzugt die Haut von Schulter und Axilla besiedelt [4]. Operationen, bei denen Fremdmaterialien eingebracht werden (z. B. Gelenkersatz in der Orthopädie), sind mit einem besonders hohen Risiko für SSI verbunden. Da die Materialeigenschaften des Implantats die Anhaftung von Bakterien begünstigen (Biofilmbildung), sind möglicherweise weniger Erreger nötig, um eine Infektion zu verursachen. Dieses Risiko kann jedoch durch die Verwendung spezieller Materialien wie Titan oder antiseptischer Beschichtungen gemindert werden [1].
Je nach Operation spielen unterschiedliche Erreger eine Rolle bei SSI. Daher ist die Umsetzung der in den Leitlinien empfohlenen Hygienemaßnahmen zur Vorbereitung des Patienten von grundlegender Bedeutung [1, 5]. Da das Risiko von SSI nicht nur von der patienteneigenen Flora (endogen), sondern auch von Flächen, Instrumenten und Händen ausgeht (exogen), ist die Einhaltung von Hygienemaßnahmen (z.B. indizierte Hände-, Flächen- und Instrumentendesinfektion) zur Vermeidung von Infektionen und zur Erhöhung der Patientensicherheit unerlässlich.
Quellen: